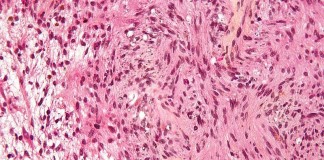

Medical Press es un portal sin ánimo de lucro, líder en España sobre estudios científicos en la área de la medicina.
Todos los estudios científicos publicados son redactados por profesionales de la salud y incluyen la fuente del estudio.
Los materiales contenidos en este sitio web no constituyen consejo médico o farmacéutico, que se debería pedir a los asesores médicos y farmacéuticos cualificados.
Todos los estudios científicos publicados son redactados por profesionales de la salud y incluyen la fuente del estudio.
Los materiales contenidos en este sitio web no constituyen consejo médico o farmacéutico, que se debería pedir a los asesores médicos y farmacéuticos cualificados.
Contáctanos: [email protected]
© 2024 Medical Press